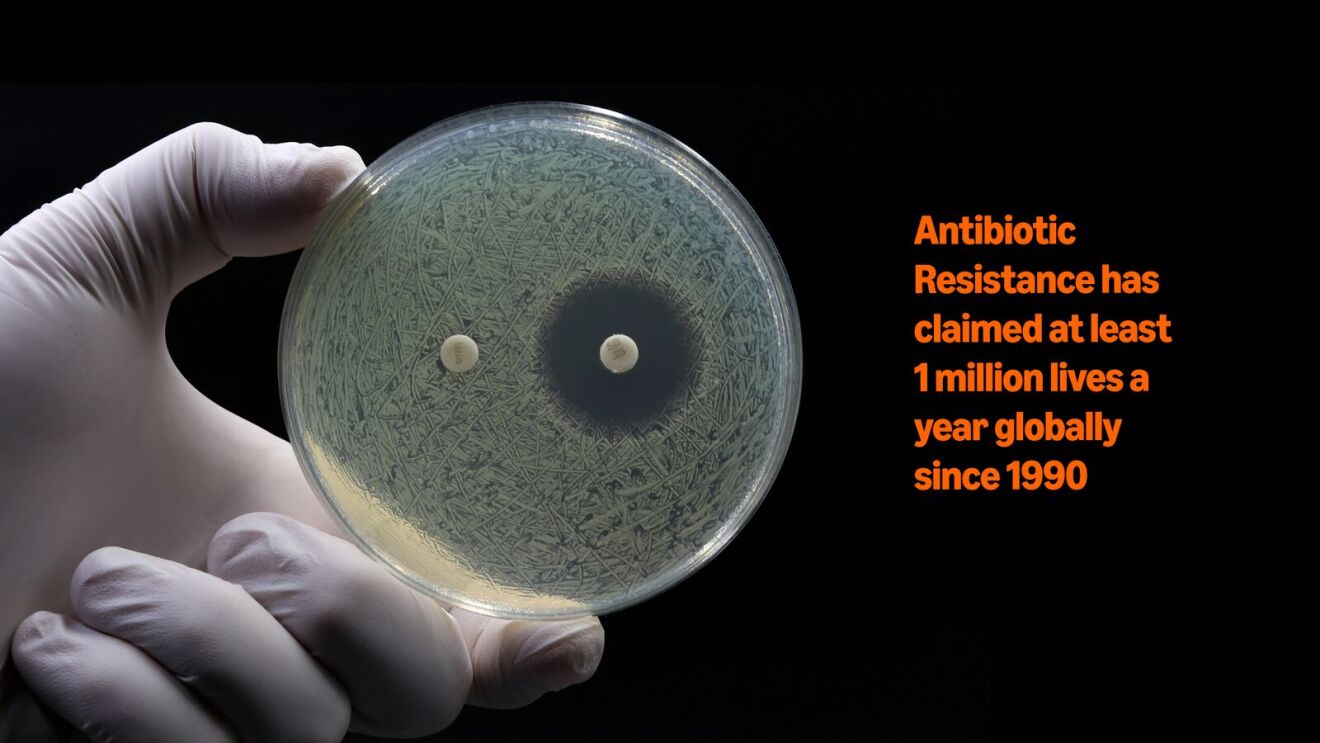
Petri dish showing antibiotic resistance, with stark warning about global mortality

Key takeaways
- French startup Phagos uses AWS to develop AI models that match phages with specific bacteria, offering a precision alternative to broad-spectrum antibiotics.
 - Phages are microscopic, self-replicating predators of bacteria.
 - By using AI to overcome the trial-and-error challenge of phage matching, Phagos aims to combat the global antibiotic resistance crisis that claims 1 million lives annually.
 - The AWS Generative AI Accelerator Program provided Phagos with cloud credits, mentorship, and embedded AWS experts in the business to help accelerate infrastructure development.
 
For French startup Phagos, the first match was an easy one. Microbiologist Adèle James and economist Alexandros Pantalis met at a startup incubator in Paris where technical founders are paired with business founders, with the aim of creating high-tech companies with the potential to “shape mankind’s future.”
Four years later, Phagos, the AI tech-bio company they started, is taking on that challenge by pursuing what has historically proved to be a much harder game of matching pairs: identifying natural phages to kill specific bacteria that cause disease.
Their ultimate goal is to overcome the global crisis of antibiotic resistance, which, according to the Global Research on Antimicrobial Resistance Project, has claimed at least 1 million lives a year since 1990.
How phages target bacteria with precision

“A phage is the opposite of an antibiotic,” said Pantalis. “An antibiotic is like a bomb. It destroys everything in its path. Whereas a phage is a very precise tool.”
That precision is one part of what gives phage therapy such huge potential. The other is that phages—microscopic, self-replicating predators of bacteria—evolve alongside their prey. This means that unlike manmade antibiotics, phages constantly readapt to overcome resistance from bacteria.
Humans have understood the power of phages for centuries. The challenge, and the reason these microscopic missiles have yet to be used at scale, is that matching the right phage with the bacteria it’s fit to destroy has been largely a matter of trial and error.
“Everything had to be done by hand,” said Pantalis. “You had to screen every single phage against every single bacterial strain. And then—even worse—every phage combination against every target bacterial strain combination. It’s an exponential problem, and one that’s impossible to be solved manually.” 
Accelerating phage prediction with generative AI

To put this in context: there are an estimated 1031 phage particles on the planet, a figure that translates as something like a trillion phages for every grain of sand in the world.
It’s here that artificial intelligence—and Amazon Web Services—come in. For over six months, Phagos employees have been working alongside a team of full-time AWS cloud architects and machine learning engineers who’ve been embedded in the business.
This hands-on, technical support is just one of the benefits Phagos received as one of a worldwide group of promising startups selected for the 2024 AWS Generative AI Accelerator Program.
Thanks to the support from AWS, Phagos is changing all that with a platform that uses generative AI to match bacterial strains with effective phages. With training data from public databases and its own lab-generated data, Phagos’s AI models will predict which phages are the most effective against any given infection—without the need for exhaustive trial and error.
“Now we’re getting closer to being able to actually read into the DNA and see if there’s going to be an interaction between a phage and a bacteria,” said Pantalis. “This changes the game.”
Going viral

When Pantalis met James, he was excited to be encountering a whole new world through the microbiologist’s know-how. “I’d been involved in some startups in the tech field, but not biotech. And when she was saying she could do genetic modifications on her own, it was like science fiction to me. I just didn’t think it was possible for a single person to do that with such limited means,” said Pantalis.
Phagos conducted its first tests on oysters. “We found an oyster farm in France and the farmer was absolutely desperate,” said Pantalis. With just $4,000, they rented a lab bench, bought some basic equipment, and James managed to use phages to demonstrate a 40% reduction in mortality in infected oysters.
“It was a small miracle,” said Pantalis. “This is when I started believing her. We showed proof of concept and made a lot of progress from a commercial and technical perspective.”
Since then, the team has expanded to shrimp and chicken, and then to the bovine and swine industries—dissolving phages in drinking water to deliver a simple, scalable solution. “We tried to go for the simplest thing,” said James. “You just dilute them in the tank, then the tank feeds the water to all the animals.”
Hands on, technical support
While human health remains the long-term ambition—they hope to be moving into the space by 2030—Phagos is currently focused on animal health. “This is actually where most of the antibiotics are used in volume,” said James.
Animal antibiotic dependency, she says, has an impact on humans too, since antibiotic-resistant bacteria don’t just stay in the barn. They spread, share genes, and eventually jump to humans. “Our whole environment is contaminated,” said James. “Bacteria can share genes, making them very easily resistant to antibiotics.”
“The AWS accelerator program changed everything,” she continued. “We received AWS credits (to offset the cost of using AWS services), but the biggest help has been having AWS experts working for us.”
That includes full-time cloud architects and machine learning engineers who’ve been helping the team fine-tune and optimize their infrastructure.
“It’s difficult to know where we’d be without it,” said James. “I think we’ve become much faster, and we’ve spent way less time figuring out how to set up our infrastructure thanks to AWS.”
That infrastructure is now the backbone of how Phagos plans to scale. The more data it collects, the smarter its models become. “Every time we deliver a new phage cocktail, we have more information, we have more biological resources,” said Pantalis. “It improves our platform so that the next phage cocktail is better than the previous one.”
Building a AI model for microbiology

And there’s been another surprising transformation: Phagos isn’t just a tech-bio company. It’s becoming a model builder, in AI terms. “We’ve been classified as a model builder, which is quite rare for a microbiology company,” said Pantalis. “Now basically a quarter of the company is just data and machine learning.”
With AWS’s help, it has built the infrastructure, vision, and technical ability to develop a model that doesn’t exist anywhere else in microbiology. “We pushed the entire technological development of the company in that direction,” he said.
What started as an experiment in a French lab is now something far bigger. The goal is bold: to develop natural and resistance-proof antimicrobials. And while others chase generic phage cocktails, Phagos is betting on personalized therapy at scale—adaptive, fast, and increasingly autonomous. “Our mission,” said Pantalis, “is to solve bacterial infections.”
Apply to the 2025 AWS Generative AI Accelerator
Applications are now open for the 2025 AWS Generative AI Accelerator (GAIA), an 8-week global program designed to fast-track the most promising generative and agentic AI startups from around the world.
The deadline to apply is July 10. Accepted startups receive:
- Up to $1 million in AWS Promotional Credits to build, train, and launch AI solutions
 - Personalized mentorship from AWS experts and industry leaders
 - Access to a curated network of partners and investors
 - Hands-on support to accelerate product development and go-to-market
 - Exclusive experiences and complimentary tickets for AWS re:Invent
 
Trending news and stories
- Amazon’s new AI-powered shopping feature ‘Help Me Decide’ makes it easy to quickly pick the right product
 - 3 ways Amazon is supporting creative industries in the digital age
 - AWS activates Project Rainier: One of the world’s largest AI compute clusters comes online
 - How Amazon prepares delivery drivers for safety and success on the road
 











